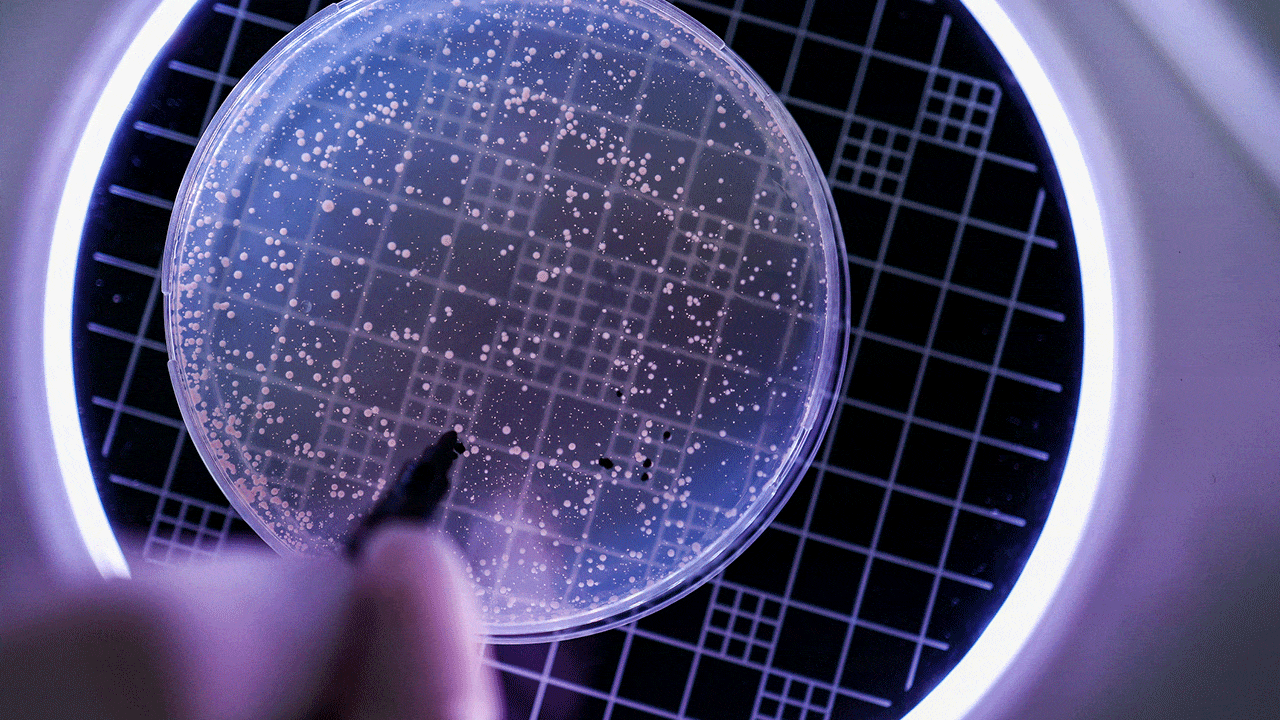

How many bacterial species are contained in the oral microbiome?
 wildpixel / iStock / Getty Images Plus
wildpixel / iStock / Getty Images Plus
What proportion of oral bacteria can’t yet be grown in culture?
Gorkem Yorulmaz / E+
Gorkem Yorulmaz / E+
Which bacteria are most strongly associated with periodontal diseases?
 Gilnature / iStock / Getty Images Plus
Gilnature / iStock / Getty Images Plus

